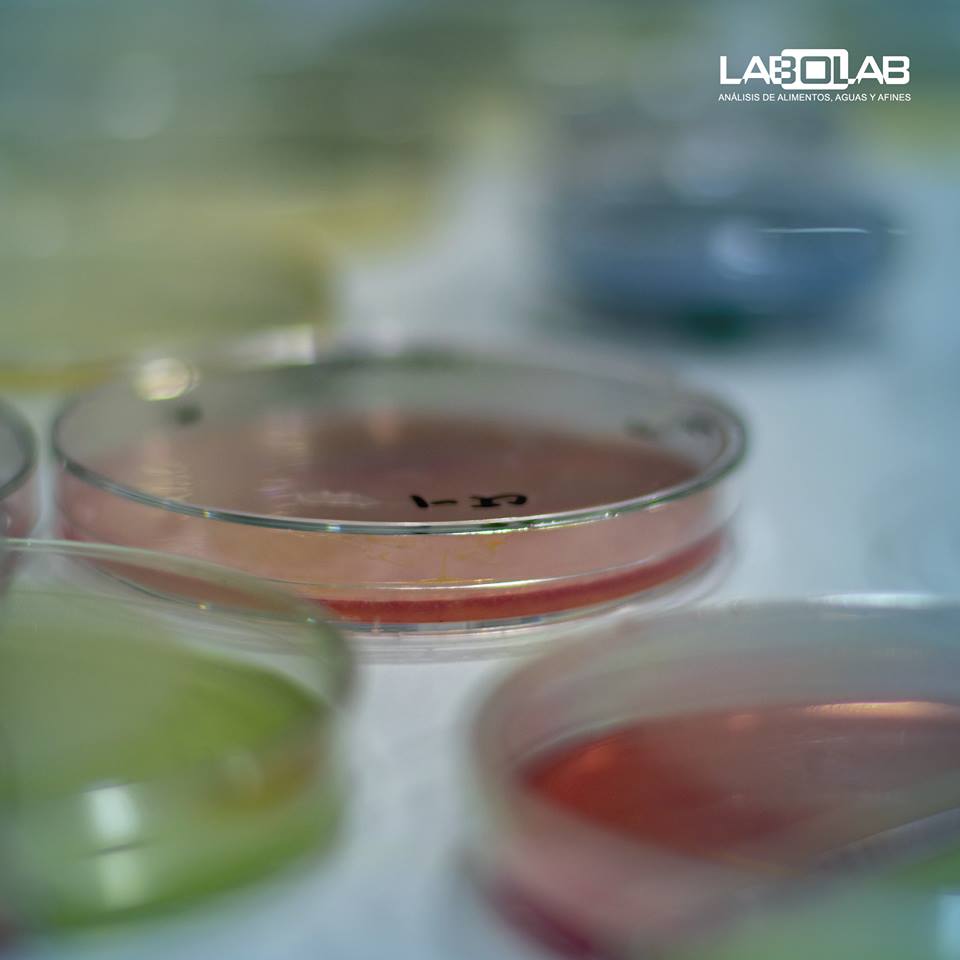

LABOLAB_EC @LABOLAB_EC
LABOLAB es un laboratorio dedicado al análisis de alimentos, aguas, materias primas, productos químicos, cosméticos, entre otros. labolab.com.ec Quito, Ecuador Joined September 2017-
Tweets98
-
Followers156
-
Following683
-
Likes0
Llegó el último mes y con este mes, una nueva oportunidad para cumplir metas y objetivos. ¡La familia LABOLAB les desea un feliz último mes del año!
¿Ya conocen cómo se ve nuestra nueva página web? Visítenla a través del siguiente link labolab.com.ec
¿Necesitas analizar productos relacionados con la industria agrícola? Más información en: labolab.com.ec [email protected] (02) 256-3225
Si necesita comunicarse con nosotros, no dude en escribirnos a [email protected] o llamarnos al (02) 256-3225.
En LABOLAB realizamos análisis microbiológicos para verificar la inocuidad y limpieza de los productos, ambientes, superficies y manos. Más información en: labolab.com.ec [email protected] (02) 256-3225
Como parte de nuestra amplia gama de análisis para la industria, se incluyen ensayos fisicoquímicos de alimentos, aguas de consumo y residuales, materias primas de productos químicos, cosméticos y farmacéuticos.
¿Necesitas analizar carnes o mariscos? En LABOLAB realizamos análisis microbiológicos y fisioquímicos de cárnicos y mariscos con el fin de garantizar alimentos saludables para el consumo humano. Más información en: labolab.com.ec [email protected] (02) 256-3225
LABOLAB dispone de un procedimiento de manejo de muestras que permite la confiabilidad de sus ensayos, desde el ingreso de estas al laboratorio hasta la emisión de resultados involucrando el correcto manejo de los factores que intervienen en nuestro Sistema de Gestión de Calidad.
¿Sabías que también realizamos análisis de balanceados? En LABOLAB realizamos análisis microbiológicos y fisioquímicos de harinas de origen animal. Más información en: labolab.com.ec [email protected] (02) 256-3225
Los invitamos a conocer más sobre los servicios que ofrecemos en nuestra página web: labolab.com.ec
Los invitamos a conocer más sobre los servicios que ofrecemos en nuestra página web: labolab.com.ec
Lo importante es ser una de las excepciones. #Emprendimiento
¡LABOLAB les desea un lindo día! #Emprendimiento
¿Quieres producir productos de panificación? En LABOLAB realizamos análisis microbiológicos y fisioquímicos de productos de cereales, harinas, pastas alimenticias, galletas, pan, snacks, etc. Más información en: labolab.com.ec [email protected] (02) 256-3225

CTASCAL @ctascal
1 Followers 46 Following ¡Laboratorio en Liquidación! Equipamiento Premium a Precios Insuperables. Cromatografía líquida, de gases, UPLC y más Revisa la colección completa
Carolina Castellanos @Krol_Kst
42 Followers 238 Following Ejecutiva Comercial l Sostenibilidad Empresarial
Fabián Torres @fmtl1979
21 Followers 512 Following Ingeniero civil, con amplia experiencia en proyectos de consultoría en el área hidráulica y sanitaria.
ZOMBENE EUGENIO @FERNAND12721449
96 Followers 942 Following
Carlos Panata @CEPanata
992 Followers 2K Following Abogado - especializado en Derecho Laboral y Seguridad Social - Asesoría y consultoría legal en Derecho Laboral y Seguridad Social.
Felipe A. Cruz @FelipeCruz_593
5K Followers 5K Following 🚫 trolls. fakes, wokes.🚫 La suerte, es el cruce de caminos, donde la búsqueda y el talento, se encuentran con la oportunidad.
Eduardo Alvarado @Teoready
13 Followers 70 Following
ARVB @alexisvillacres
109 Followers 140 Following “Yo soy yo y mi circunstancia, y si no la salvo a ella no me salvo yo”
Zoberbac Agrocompany @Zoberbac
1K Followers 3K Following Nutrición y protección de #cultivos para el #agricultor del siglo XXI. Soluciones de #agricultura tecnológicamente avanzadas, rentables y sostenibles.
Geovanna Puente @puente_geovanna
76 Followers 315 Following Abogada | Propiedad Intelectual | Asesoría empresarial | Con corazón violeta 💜
Isviona Nature @IsvionaN
9 Followers 171 Following Isviona Nature, jabones artesanales elaborados con los mejores productos naturales, ideales para el cuidado de todo tipo de piel.
#Ramiro @somosloscaras
325 Followers 571 Following Tio, Gastrónomo, Emprendedor, Activista Político, Deportivo y Cultural. 👉🏼#RepublicaDeLosCaras #Sucre #Manabi #Voluntariado #22 #turismo
Oscar Chávez @ochavezcuenca
447 Followers 3K Following Magister en Administración de Empresas, mezcla de experiencia y formación, generador de valor para las empresas, la ética y la moral valores NO negociables
Geovanny Espinoza @GeovannyEG
288 Followers 1K Following Desarrollo Territorial Rural |@FLACSOec Food, Culture & Social Justice |@OregonState Lecturer |@Occidental Profesor postgrado |@PUCE_Manabi; @IAENUniversidad
OpenRevolution @Open_Revolution
388 Followers 2K Following Consultoría en programas de software libre y soluciones de infraestructura para empresas.
Boone @Boonetrov
55 Followers 395 Following
Valerinatrina @BravaPapa
33 Followers 308 Following
Fundación CAJE @FundacionCaje
475 Followers 245 Following Organización sin fines de lucro. Nuestra misión es promover oportunidades y espacios reales para el desarrollo integral. 👍🏻(ONG) ☎️2724565
CarmeloR.A 🍍 @CRA55
565 Followers 1K Following Con la sonrisa despeinada de ir en contra de los vientos.
TDT FILMS STREAMING @TDTSTREAMING
27 Followers 328 Following
Marco Culqui-Sánchez... @MarcoCulquiMD
2K Followers 5K Following Médico 👨⚕️ Master Epidemiología e Investigación Clínica / Internista en proceso
Alberto José Rodríg... @Beto_JRodF
821 Followers 2K Following ♻️MÁSTER GESTIÓN AMBIENTAL Y ENERGÉTICA ⚡|Gerente Gestión Ambiental EERSSA, Gerente Gestión Ambiental GADML, Gerente Gestión Sostenible, Gestión de Residuos🌳
Nelly Morales @nellymoralez
20 Followers 104 Following Magister en Gerencia Empresarial, Ing en Administración de Empresas. Consultora.
Oswaldo Gaston Redrov... @OSWALDOGASTON
81 Followers 292 Following Escritor, periodista y abogado. Dr. en Jurisprudencia. Magister en Derecho Laboral. Soy de izquierda y tolerante con el resto de ideologias
Maria Jose Flores O @MajoFlores82
242 Followers 1K Following Para ser feliz hay que amar lo que uno hace.. Yo amo la oportunidad de aprender cada día y a mis bebes chiquitos 👦🏻🧒🏻 que son el mejor regalo
Andres Borja @AndresB84036901
7 Followers 73 Following
Roberto Moyano G @christrealtor01
138 Followers 1K Following productor y comerciante de la costa Ecuatoriana, creyente en las oportunidades equitativas para todos los ciudadanos sin distinción de raza o nivel socioeconóm
Guayaco82 @josereyesj82
194 Followers 2K Following
J David Bedoya 🇪�... @JDavidBedoya2
16 Followers 91 Following Ing. Zamorano 🚜 🌎 Ecuadorian 🇪🇨 💪😎 Agribusiness passion🌱🐄🐖🌳 Current location Quito, ECU 📍
Wellington Bastidas @waubas
483 Followers 5K Following Agrónomo de profesión, filósofo de pasión. Agua para la vida y el progreso.
Fernando Navarrete @JFNM1
255 Followers 4K Following
Antena 7 Radio y Tele... @7Antena
171 Followers 647 Following Espacio de noticias, análisis y opinión. Síguenos en: Facebook: @antena7radio Instagram: @7antena
PPD Ecuador @PPDEcuador
2K Followers 4K Following El Programa de Pequeñas Donaciones (PPD) es un fondo semilla que busca dar respuestas locales a problemas ambientales globales.
Ffff @smorocho2019
23 Followers 1K Following
Verónica Ruano @VeroiRZ
108 Followers 385 Following
Pablo Burbano @BurbanoPablo
34 Followers 802 Following Católico, Mi Familia, Agricultura Sostenible, Caballos, LDU.
santiago @chino_hn
14 Followers 454 Following
Carlos Luis Martinez @CLME1965
82 Followers 649 Following "Economista de profesión y Agricultor por vocación". Director Ejecutivo de la Cámara de Agricultura II zona
Abogados yAsesoria en... @AseConPublEc
756 Followers 1K Following Asesoría profesional en Contratación pública, tanto para entidades como proveedores. Contáctenos al 0999950265
Walter Pérez @walterperezuv
52 Followers 52 Following Trabajo en el Servicio de Acreditacion Ecuatoriano
Yaku @malejitacc
323 Followers 3K Following El encanto de haber nacido en las arrugas de esta Tierra:Ecuador. Mis pasiones: viajar,aprender,culturas, armonía de vida
Juan Sebastián Vela @juanvela19
52 Followers 1K Following
Fernando Alvarez P @nando_a85
88 Followers 402 Following Ganadero, Magíster en Gestión y Desarrollo Social, Ingeniero Comercial, candidato al GAD Victoria Portete, Dios sobre todas las cosas.
Acreditación EC @SAE_EC
5K Followers 770 Following Entidad Oficial de Acreditación en Ecuador. ¡Acreditamos para Ecuador!
S. Elizabeth Monteneg... @Sthefanie_MT
108 Followers 1K Following Abogado - Proyect Managemet - Ucabista Venezolana y ecuatoriana 🇪🇨&🇻🇪
P.Calderón @elpatocalderon
331 Followers 355 Following Montubio con Disfraz de Ejecutivo. Ing. Agrónomo, Asesor en Seguros Agrarios. Msc. Marketing y Dirección Comercial, Pro Tattoo, Maestro Asador.
Paola Martinez @paomartinez2012
170 Followers 799 Following
El Mago @JovenMAGricola
55 Followers 312 Following Profesional, buscando un futuro adecuado y respaldando los procesos correctos que realice cada gobierno, desmintiendo las falacias de algunos actores.
Reserva Marina de Gal... @RMGalapagos
179 Followers 334 Following
Isra VJ. @odnuges_learsi
231 Followers 525 Following Ecuatoriano, Latacungeño de alma y corazón. Ing. Agropecuario, Master Gestión Calidad. Amo mi vida, mi ser y mi entorno
Geovanny Espinoza @GeovannyEG
288 Followers 1K Following Desarrollo Territorial Rural |@FLACSOec Food, Culture & Social Justice |@OregonState Lecturer |@Occidental Profesor postgrado |@PUCE_Manabi; @IAENUniversidad
Javier Andres Aragund... @aragundi_javier
45 Followers 277 Following Político. La democracia es el Gobierno del pueblo,por el pueblo y para el pueblo
CarmeloR.A 🍍 @CRA55
565 Followers 1K Following Con la sonrisa despeinada de ir en contra de los vientos.
Carolina Castile @CarolinaCastile
2K Followers 525 Following Liquid and bar Castile Soaps. [email protected] Available on @Amazon US and Europe
J.R Acosta Motos @jram1411
2K Followers 2K Following Postdoc Plant Physiologist at @HiTechUCAM and @UCAM, cooperation with @CEBAS_CSIC and @IB_UMH. Música, cine y literatura #SinCienciaNoHayFuturo
Hector Ballesteros @h_ballesteros
448 Followers 1K Following Promocionando Comercio & inversiones Sustainable & inclusive agrifood chains
Solanda Guadamud @SolandaGuada
6 Followers 165 Following Mujer, luchadora por los derechos humanos, guayaquileña madera de guerrera
HENRY MEDINA @henrylenin
61 Followers 178 Following Procura nunca salir de tu casa enojado con aquellos que amas, la vida puede cambiar en un segundo, tal vez nunca te despidas.
Miguel Antonio @MigueMoreira84
133 Followers 207 Following Asesor Estudiantil - Emprendimientos - Agronegocios - Agroindustrias.
Sebastian Gallegos @Seb_gal89
16 Followers 113 Following
Santiago Arroyo @santiarroyob
67 Followers 213 Following
Holliday Food🍕🌱 @87Food_Scott
54K Followers 40K Following I love 🄵🄾🄾🄳 🌱 #ProperChips, #NeapolitanPizza, family man, marketing exec and a Blackpool lad 🍊 .
Mikuna Asesoria @mikuna_asesoria
65 Followers 443 Following
JabaPloc® @JabaPloc
3K Followers 283 Following Inteligencia y creatividad al servicio de la humanidad.
DANILO CHANGUIN @DaniloChanguin
57 Followers 378 Following 100% Manaba. Agricultor por vocación. PRO FAMILIA COMO DIOS MANDA... Y por supuesto el glorioso CS EMELEC
AGROSCOPIO.COM @agroscopio
280 Followers 448 Following Descubre en https://t.co/IcWl28lOfB la mejor selección de maquinaria, tractores e implementos Agrícolas . ¡Todo lo que necesitas para potenciar tu cosecha!
Eurofins Agro Ecuador @Eurofins_AgroEC
326 Followers 926 Following Laboratorios a nivel mundial de suelo, agua, foliar, fitopatológico, ganadería, pesticidas y ambientales para la floricultura y la agricultura
Gustavo Rivas T.🇨�... @rivas_gustavo
358 Followers 2K Following Profesional en 💪#Logística, #Operaciones Comerciales, #Inventarios.Hijo, Hermano, Esposo, Padre, Amo mi Familia, La Justicia, El Vino, ¡SI ES CHILENO ES BUENO!
Juan Carlos Cassinell... @JCCassinelli
39K Followers 2K Following Doctor en Leyes. Presidente Emérito Cámara Ecu-Ita. Director de @TradeEcuador, @ambielegsa y @cassinelliabg. Articulista. Ex Ministro de Comercio Exterior.
Lautaro Villacis @lvillacis1
284 Followers 1K Following
Agritotal @agritotal
33K Followers 27K Following El sitio más completo de noticias e informes técnicos del sector agropecuario. https://t.co/y2sJblW4ka TODO EL CAMPO EN INTERNET.
Andres Fernandez @AndresF_Cas
213 Followers 849 Following Pasion por el Agro,un nuevo amanecer por nuestro sector
Jose cornelio @jdelacruzlanti
8 Followers 267 Following
🇪🇨Ecuador Marí... @EcuadorMaritima
4K Followers 5K Following MAGAZINE DIGITAL ⚓️#Ecuador #NoticiasEcuador #PublicidadEcuador 🌎 Ceo @MFuentesP #Logística🚢 Sigue: @maritimaport
Boone @Boonetrov
55 Followers 395 Following
Diego Mierez @dmierez08
95 Followers 183 Following 🗣 Estudiante en @platzi 💪 Ingeniería, matemáticas, estadística y ciencia de datos.
XALU CORP @xalucorp
81 Followers 149 Following XaluCorp es una empresa dedicada a la producción y comercialización de bebidas refrescantes, nutricionales y proteicas que promueven un estilo de vida saludable
DorliagroSA @DorliaSa
24 Followers 46 Following Brindamos servicios y productos de calidad, enfocados en el desarrollo sostenible de nuestros agricultores procurando la producción de alimentos sanos.
Carolina Castellanos @Krol_Kst
42 Followers 238 Following Ejecutiva Comercial l Sostenibilidad Empresarial
Jason Anson @jasonanson
30K Followers 45 Following
GPS Group @gpsgroupec
344 Followers 700 Following "Lideramos la transición energética y ecológica del sector camaronero ecuatoriano". #acuaculturadelfuturo Contáctanos: 0982204506 - [email protected]